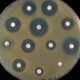
Método de Kirby-Bauer

La clasificación de los antibióticos en bactericidas y bacteriostáticos se basa en su capacidad para matar directamente o suprimir el crecimiento bacteriano. Los antibióticos bacteriostáticos dependen del sistema inmunológico del paciente para eliminar las bacterias debilitadas. La elección del tipo de antibiótico depende de varios factores, incluida la gravedad de la infección y la respuesta del sistema inmunológico del paciente.
La distinción entre antibióticos bactericidas y bacteriostáticos es fundamental en la farmacología y el tratamiento de infecciones bacterianas. Estas dos categorías de antibióticos difieren en su mecanismo de acción y en el efecto que tienen sobre las bacterias.
<
Antibióticos BactericidasLos antibióticos bactericidas son aquellos que tienen la capacidad de matar directamente a las bacterias. Actúan de diversas maneras para llevar a cabo esta función:
- Lisis Celular: Algunos antibióticos bactericidas causan la lisis (ruptura) de la membrana celular bacteriana, lo que conduce a la muerte de la bacteria.
- Inhibición de Componentes Vitales: Otros antibióticos interfieren con procesos esenciales en la bacteria, como la síntesis de la pared celular, la replicación del ADN o la síntesis de proteínas, lo que provoca la muerte de la bacteria al detener su crecimiento y reproducción.
- Efecto Concentración-Dependiente: La eficacia de los antibióticos bactericidas suele estar relacionada con la concentración del antibiótico en el sitio de la infección. Cuanto mayor sea la concentración, más rápida y efectivamente matarán a las bacterias.
Antibióticos BacteriostáticosLos antibióticos bacteriostáticos son aquellos que suprimen el crecimiento y la reproducción de las bacterias, pero no las matan directamente. Estos antibióticos actúan de la siguiente manera:
- Inhibición de Procesos Vitales: Los antibióticos bacteriostáticos interfieren con procesos vitales de las bacterias, como la síntesis de proteínas o la replicación del ADN. Esto ralentiza la reproducción bacteriana sin causar la muerte inmediata de las bacterias.
- Efecto Concentración-Dependiente: Al igual que los antibióticos bactericidas, la efectividad de los antibióticos bacteriostáticos también está relacionada con su concentración en el sitio de la infección. Cuanto mayor sea la concentración, más eficaz será la supresión del crecimiento bacteriano.
Papel del Sistema InmunológicoLos antibióticos bacteriostáticos dependen del sistema inmunológico del paciente para erradicar las bacterias que no se multiplican. Esto se debe a que, aunque estos antibióticos suprimen el crecimiento bacteriano, no matan directamente a las bacterias. En lugar de eso, permiten que el sistema inmunológico del paciente reconozca y destruya las bacterias debilitadas.Es importante destacar que el sistema inmunológico es altamente eficiente en la eliminación de bacterias debilitadas, especialmente cuando se trata de infecciones menos graves o en pacientes con sistemas inmunológicos saludables. Sin embargo, en infecciones graves o en pacientes inmunocomprometidos, los antibióticos bactericidas que matan directamente a las bacterias suelen ser preferidos, ya que proporcionan una respuesta más rápida y efectiva.
Antibióticos Bacteriostáticos:
- Tetraciclina
- Eritromicina
- Cloranfenicol
- Líneazolida
- Sulfonamidas
Antibióticos Bactericidas:
- Penicilina
- Ciprofloxacina
- Vancomicina
- Gentamicina
- Metronidazol

Síguenos en X: @el_homomedicus y @enarm_intensivo Síguenos en instagram: homomedicus y en Treads.net como: Homomedicus